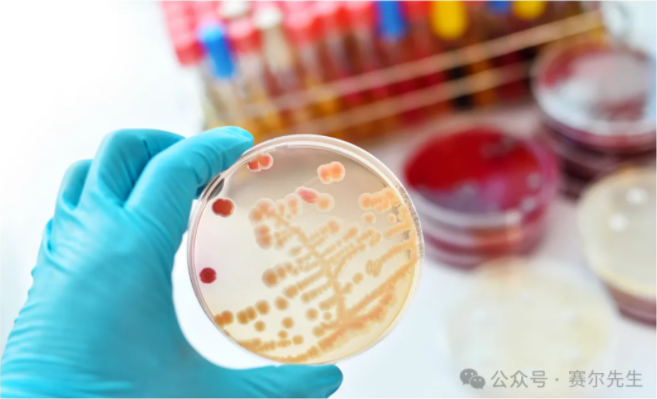
1713343546251718.png image.png

新聞中心
01
OD600的應用--幫助了解細菌的生長狀態
OD600是指在600nm波長處的吸光值,常常被用于分析細菌生長和進行抗生素敏感性測試,在細菌檢測中,測量波長需要選擇在生物材料吸光度最小的范圍內。因此,這些細菌生長曲線測量通常使用600-670nm左右的紅色波長。在細菌連續培養過程中,在不同的時間點檢測菌液的OD600值,然后以時間為橫坐標,OD600為縱坐標,描繪細菌的生長曲線。結合生長曲線,可以評估細菌所處的生長階段,進而可以確定合適的誘導表達或收獲的時間點。
02
OD600 測量菌液/細胞濃度的原理
細菌密度的測量方式是通過光的散射,也就是看渾濁程度而不是吸光度,光的散射程度反應的是細胞的生物質量而不是細胞個數,也稱濁度測量。濁度法測量非均質溶液中是否存在固體顆粒。固體顆粒可以是細胞、沉淀、聚集體或溶液中存在的任何其他固體物質。顆粒會散射光束中的光子,因此儀器檢測器會檢測到較低的光強度。這種現象與吸光度測量截然不同,吸光度測量是指光子被均勻溶液中的特定染料吸收,吸光度和濁度散射的基本區別如圖 1 所示。

圖1:吸光度和濁度散射的基本區別, 在吸光度測定中,由于光被樣品吸收,光電探測器中的光強會減弱(A);在濁度測定中,入射光由樣本中的細胞/粒子隨機產生散射。這將導致方向的不確定性。繼續沿直線傳播的光會進入檢測器,光強也會減弱(B)
03
使用不同的設備測量OD600細菌濃度可能得到不同的數值
對于具有濁度的樣品,如細菌溶液、細胞培養物,測量的“吸光值”是由于光散射,而不是溶質分子光吸收的結果。由于光散射的程度受系統光學特性(比色池和儀器出口狹縫之間的距離、單色器光學特性、狹縫幾何特性等)的影響,使用不同類型的分光光度計測量同一樣品時,可能會得到不同的OD600讀數。
那我們來看下主要有哪些原因影響濁度的測量呢?
一是濁度測量受樣品中顆粒濃度的影響
濁度測量總是在異質樣品中進行,一般需要測量96/ 384 孔板,現在多數酶標儀通常使用相當窄的測量光束。通常情況下,微孔板光度計的光束直徑不到一毫米,當光束穿過96孔板的孔時,測量光束只能覆蓋樣品體積的很小一部分(圖2)。另外,現代微孔板光度計的采樣時間也很短,通常為毫秒級,這些對于濁度測量來說并不是最佳選擇會增加變化。比如液體中的固體顆粒并非處于靜止狀態,而是在整個液體中自由漂浮。因此,當樣品中只有少量固體顆粒時,在重復測量中,相同數量的顆粒出現在光束內的概率很低。如果樣品中有100 個顆粒,那么測量光束區域內的顆粒數最有可能是1個,但隨機情況下可能是0個或2個,甚至3個。當采樣時間也以毫秒為單位時,液體中顆粒的動態流動不會明顯改變單個測量中的這種情況。因此,當OD值較低時,檢測精度可能會明顯降低,吸光度檢測的 CVs% 也會大于正常值。

同樣,當樣品中的顆粒數量增加到非常多時,從顆粒上散射的光子會撞擊到另一個顆粒并重新散射。這將導致一些散射光子經過多次散射后到達檢測器。因此,濁度測量的線性測量范圍總是低于吸光度測量。
二是不同儀器分光光度計的設計影響濁度測量
吸光度和濁度測量之間第二個非常重要的區別是,不同儀器的光學設計會影響所得到的OD值(圖 3)。因此,不同廠家生產的微孔板光度計沒法對同一樣品給出相同的OD值。這里有兩個影響因素:一是光電探測器收集窗口的大小,二是收集狹縫的大小。探測器窗口越大,收集到的輕微散射光子就越多,因此觀測到的OD 值就越低。還有一個主要問題是樣品到檢測器的距離。如果檢測器距離樣品很遠,即使是輕微散射光子也會到達檢測器;如果很近,即使是強烈散射光子也會被檢測器收集到。因此,這個距離對得出的OD 值影響也很大。由于每個制造商的光學設計不同,這兩個參數(距離和探測器的大小)在兩臺不同的儀器中永遠不會相同。這些因素不會影響吸收測定,因為在吸收測定中光束形狀保持不變。檢測器的大小或距離不會改變到達檢測器的光量。

圖示3:檢測器收集窗口的大小和與樣品的距離都會改變所測得的OD值,因此不同的儀器會對相同的樣品給出不同的OD值。檢測到的OD值差異很容易達到20-40%。
比如下圖中,在濁度測定結果的偏差表明,Multiskan Sky 和 SkyHigh 采用了非常相似的光學設計,因此結果幾乎相同,但Varioskan LUX 和 Multiskan FC 采用了不同類型的光學器件,因此與Sky和SkyHigh有很大不同,兩者之間也存在明顯差異。但在吸光度測量方面,所有四款酶標儀的測量結果完全相同。

圖示4:不同型號酶標儀檢測吸光度和濁度的比較
因此,對于OD600測量,不同酶標儀的結果不能直接進行比較。對于OD600測量,使用相同型號的分光光度計可以保障良好的重復結果。而對于不同酶標儀的結果首先需要使用適當的校準曲線進行標準化。
常規的酶標儀檢測都具備了光吸收檢測功能,賽默飛多款酶標儀具有單獨模塊用于濁度檢測,比如單功能酶標儀FC,配有比色杯模塊的Multiskan SkyHigh 以及多功能酶標儀Varioskan LUX等,都是核酸、蛋白質、菌液濃度及其他物質測量的多功能儀器,可為用戶提供完善的解決方案。


